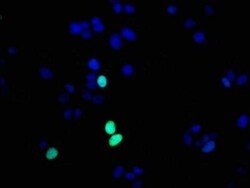
Histone H1.4, p Thr17 Antibody (3E1), Novus Biologicals:Antibodies:Primary

missing translation for 'onlineSavingsMsg'
Learn More
Learn More
Histone H1.4, p Thr17 Antibody (3E1), Novus Biologicals™
Rabbit Monoclonal Antibody
£269.00 - £406.00
Specifications
| Antigen | Histone H1.4 |
|---|---|
| Clone | 3E1 |
| Dilution | ELISA, Immunohistochemistry 1:50-1:500, Immunocytochemistry/Immunofluorescence 1:30-1:200 |
| Applications | ELISA, Immunohistochemistry, Immunocytochemistry |
| Classification | Monoclonal |
| Product Code | Brand | Quantity | Price | Quantity & Availability | |||||
|---|---|---|---|---|---|---|---|---|---|
| Product Code | Brand | Quantity | Price | Quantity & Availability | |||||
|
30026106
|
Novus Biologicals
NBP3-26420-50ul |
50 μL |
£269.00
50µL |
Please sign in to purchase this item. Need a web account? Register with us today! | |||||
|
30029174
|
Novus Biologicals
NBP3-26420-100ul |
100 μL |
£406.00
100µL |
Please sign in to purchase this item. Need a web account? Register with us today! | |||||
Description
Histone H1.4 Monoclonal antibody specifically detects Histone H1.4 in Human samples. It is validated for ELISA, Immunohistochemistry, ImmunocytochemistrySpecifications
| Histone H1.4 | |
| ELISA, Immunohistochemistry 1:50-1:500, Immunocytochemistry/Immunofluorescence 1:30-1:200 | |
| Monoclonal | |
| Purified | |
| RUO | |
| Human | |
| dJ221C16.5, H1 histone family, member 4, H1.4, H1F4H1E, histone 1, H1e, histone cluster 1, H1e, histone H1.4, Histone H1b, MGC116819 | |
| Synthesized peptide [UniProt P10412] | |
| Primary | |
| Store at -20 to -70C. Avoid freeze-thaw cycles. |
| 3E1 | |
| ELISA, Immunohistochemistry, Immunocytochemistry | |
| Unconjugated | |
| Rabbit | |
| Epigenetics | |
| PBS, pH 7.4, 150mM NaCl and 50% glycerol | |
| 3008 | |
| IgG | |
| Affinity purified |
Spot an opportunity for improvement?Share a Content Correction
Product Content Correction
Your input is important to us. Please complete this form to provide feedback related to the content on this product.
Product Title